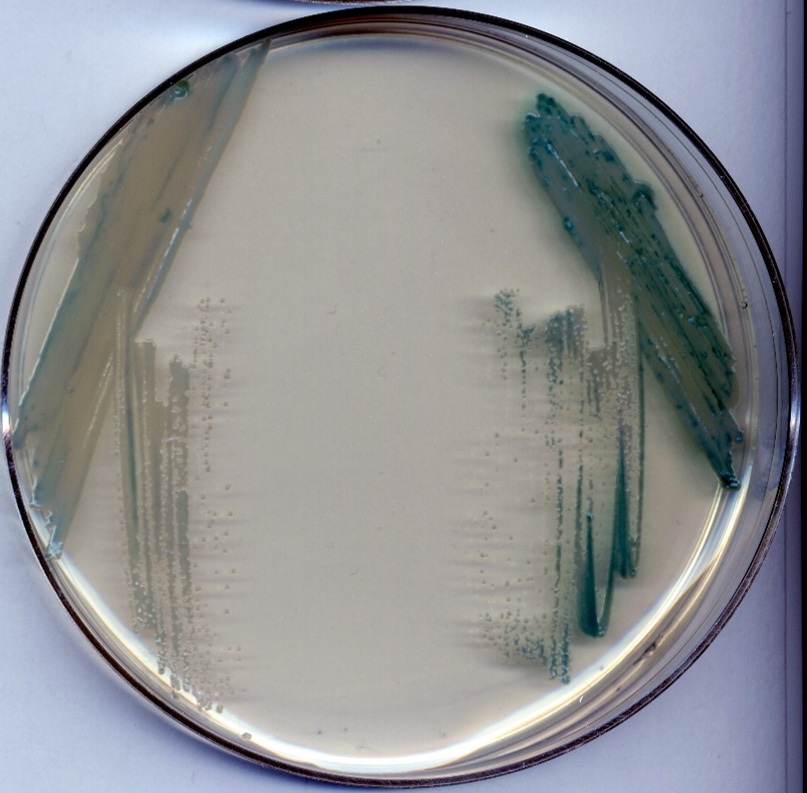

How do bacteria share their genes?
We study how bacteria share genetic material, a process known as horizontal gene transfer (HGT). A major untapped category of HGT is mediated by gene transfer agents (GTAs), phage-like particles encoded by many bacteria.

GTAs are domesticated phages that have lost the ability to selfishly replicate and instead package random genomic DNA for transfer to other cells, driving horizontal gene transfer and DNA repair.
How do we study GTAs?
we leverage genetics, imaging, and ‘omics’ approaches

Projects
What pathways induce or restrict GTA production?

Can we discover GTA systems in other species?

Can we engineer gene transfer agents to target other species of interest?

Current Members

Kevin Gozzi, Ph.D.
Principal Investigator

Amani Chinni, B.S.
Post-baccalaureate Fellow

David Zahrah, B.S.
Post-baccalaureate Fellow

Ryan Pianka
Research Assistant

Nathan Thewedros
Research Assistant
Former Members

Ella Messner, B.S.
Post-baccalaureate Fellow

Devin Lloyd, B.S.
Post-baccalaureate Fellow

Gillian McClennen, B.S.
Post-baccalaureate Fellow

Kristina Ruiz
Research Assistant

Maddie Flanagan
Research Assistant

Andrew Barnett
Research Assistant
Publications
Maria A. Schumacher, Emily Cannistraci, Raul Salinas, Devin Lloyd, Ella Messner, Kevin Gozzi. Structure of the WYL-domain containing transcription activator, DriD, in complex with ssDNA effector and DNA target site. Nucleic Acids Res. 2024 Feb 9;52(3):1435-1449. doi: 10.1093/nar/gkad1198.
Kevin Gozzi, Ngat Tran, Joshua W. Modell, Tung Le, and Michael T. Laub. 2022. “Prophage-like gene transfer agents promote Caulobacter crescentus survival and DNA repair during stationary phase.” PLoS Bio. 10.1371/journal.pbio.3001790
Kevin Gozzi, Raul Salinas, Viet D. Nguyen, Michael T. Laub, and Maria A. Schumacher. 2022. “ssDNA is an allosteric regulator of the C. crescentus SOS-independent DNA damage response transcription activator, DriD.” Genes & Development, 36, 9-10, Pp. 618–633.
Leticia Angelini, Renato Corrêa dos Santos, Gabriel Fox, Srinand Paruthiyil, Kevin Gozzi, Moshe Shemesh and Yunrong Chai. 2023. “Pulcherrimin protects Bacillus subtilis against oxidative stress during biofilm formation.” npj Biofilms and Microbiomes, 9, 50. 10.1038/s41522-023-00418-z
Gabriel T. Filsinger, Timothy M. Wannier, Felix B. Pedersen, Isaac D. Lutz, Julie Zhang, Devon A. Stork, Anik Debnath, Kevin Gozzi, Helene Kuchwara, Verena Volf, Stan Wang, Xavier Rios, Christopher J. Gregg, Marc J. Lajoie, Seth L. Shipman, John Aach, Michael T. Laub, and George M. Church. 2021. “Characterizing the portability of phage-encoded homologous recombination proteins.” Nature Chemical Biology, 17, 4.
Jennifer Greenwich, Alicyn Reverdy, Kevin Gozzi, Grace Di Cecco, Tommy Tashjian, Veronica Godoy-Carter, and Yunrong Chai. 2019. “A decrease in serine levels during growth transition triggers biofilm formation in Bacillus subtilis.” Journal of Bacteriology, 201, 15.
Leonor García-Bayona, Kevin Gozzi, and Michael T. Laub. 2019. “Mechanisms of resistance to the contact-dependent bacteriocin CdzC/D in Caulobacter crescentus.” Journal of Bacteriology, 201, 8, Pp. e00538–18.
Kevin Gozzi and Yunrong Chai. 2018. “Acetic acid is an important modulator for intracellular function and interspecies communication in bacteria.” In Acetic Acids: Advances in Research and Applications.
Yinghao He, Kevin Gozzi, Yuxuan Qin, and Yunrong Chai. 2018. “Investigating a novel regulation on a checkpoint protein Sda that is essential for biofilm formation and sporulation in Bacillus subtilis.” The FASEB Journal, 32, S1.
Alicyn Reverdy, Yun Chen, Evan Hunter, Kevin Gozzi, and Yunrong Chai. 2018. “Protein lysine acetylation plays a regulatory role in Bacillus subtilis multicellularity.” PLoS ONE, 13, 9.
Kevin Gozzi, Carly Ching, Srinand Paruthiyil, Yinjuan Zhao, Veronica Godoy-Carter, and Yunrong Chai. 2017. “Bacillus subtilis utilizes the DNA damage response to manage multicellular development.” npj Biofilms and Microbiomes, 3, 1.
Cameron Habib, Yiyang Yu, Kevin Gozzi, Carly Ching, Moshe Shemesh, and Yunrong Chai. 2017. “Characterization of the regulation of a plant polysaccharide utilization operon and its role in biofilm formation in Bacillus subtilis.” PLoS ONE, 12, 6.
Fang Yan, Yiyang Yu, Kevin Gozzi, Yun Chen, Jianhua Guo, and Yunrong Chai. 2017. “Genome-wide investigation of biofilm formation in Bacillus cereus.” Applied and Environmental Microbiology, 83, 13.Abstract
Jacob Barlow*, Kevin Gozzi*, Chase P. Kelley, Benjamin M. Geilich, Thomas J. Webster, Yunrong Chai, Srinivas Sridhar, and Anne L. van de Ven. 2017. “High throughput microencapsulation of Bacillus subtilis in semi-permeable biodegradable polymersomes for selenium remediation.” Applied Microbiology and Biotechnology, 101, 1.
Carly Ching, Kevin Gozzi, Björn Heinemann, Yunrong Chai, and Veronica G. Godoy. 2017. “RNA-mediated cis regulation in Acinetobacter baumannii modulates stress-induced phenotypic variation.” Journal of Bacteriology, 199, 11.
Yun Chen, Kevin Gozzi, Fang Yan, and Yunrong Chai. 2015. “Acetic acid acts as a volatile signal to stimulate bacterial biofilm formation.” mBio, 6, 3.
Yun Chen*, Kevin Gozzi*, and Yunrong Chai. 2015. “A bacterial volatile signal for biofilm formation.” Microbial Cell 2 (10).
We’re hiring!
We would love to have you join us. Email inquiries to Kevin at kgozzi@fas.harvard.edu.
Postdoctoral applicants:
We invite applications from postdoctoral candidates with backgrounds in microbiology and molecular biology. Applicants will benefit directly from the interdisciplinary core facilities at the Rowland Institute at Harvard and will be encouraged to participate in the Harvard and Boston scientific community. Harvard University postdocs are offered competitive salaries and comprehensive benefits packages.
To apply, please send the following to kgozzi@rowland.harvard.edu:
A cover letter describing past, current, and future research interests
A curriculum vitae
A list of contact information for up to 3 references



